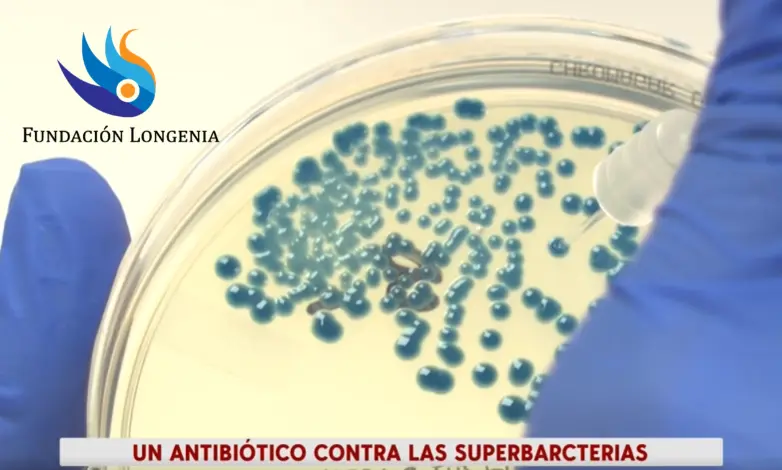

Descubren cómo frenar la metástasis del cáncer de mama antes de que comience
Un equipo liderado por el Instituto de Investigación del Hospital del Mar de Barcelona, con participación de GEICAM, ha identificado la proteína TIM-3 como clave en la fase más temprana de la metástasis de cáncer de mama. Al bloquear TIM-3, las “semillas” tumorales...
El órgano que envejece primero según la ciencia china y podría marcar el inicio del deterioro humano
Un reciente estudio de la Academia China de Ciencias, publicado en Cell, analiza perfiles proteómicos a lo largo de 50 años y concluye que la aorta es el primer órgano en mostrar señales de envejecimiento, con variaciones en proteínas como GAS6 a partir de los 30...
Físico de 90 años se une a ensayo experimental para desafiar los límites de la longevidad saludable
John G. Cramer, físico emérito de 90 años, se convierte en el primer receptor de un trasplante mitocondrial autólogo cultivado en biorreactores, en un estudio pionero de longevidad liderado por Mitrix Bio. La Fundación Longenia celebra este hito científico como un...
Avances más recientes con la Lariocidina, una nueva clase de antibiótico contra las superbacterias
De péptido “lazo” prometedor a candidato clínico: optimización de producción y nuevas estrategias terapéuticas. En marzo de 2025, la revista Nature presentó la lariocidina, un antibiótico lasso-péptido capaz de inhibir el ribosoma bacteriano y derrotar cepas...